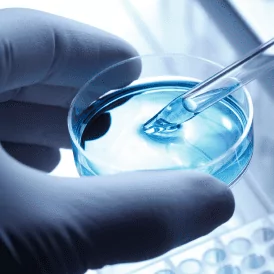

Bacillus-based cleaning ingredients make stronger solutions.
Our Bacillus strains break down and reduce waste rather than cover it up.
With world-class research and development, we help industrial and institutional manufacturers and distributors produce effective cleaning products with trusted biological concentrates.
Effective ingredients. Proven Success.
All of our microbial strains go through frequent, rigorous testing to ensure the highest-quality ingredients are delivered to our clients, and we have the data to prove they work.
Our industrial and institutional product line, SporActiv®, serves a multitude of cleaning needs for applications like drains, grease traps, septic tanks, and more.

Education, Tools, and Hands-On Support
With us, collaboration doesn’t end after we ship the product. Our partners’ success includes blending and formulation support as well as training and sales materials, so that the finished product, and its marketing, are effective.
Learn more about our support

Powerful Cleaning for Multiple Purposes
Our SporActiv® ingredients are suitable for a wide variety of applications, from surface cleaning to septic system maintenance. When you work with us, we help you find the product that best fits your formulation needs and business goals.
Learn more
Bacillus-based ingredients make stronger cleaning solutions.
Our Bacillus strains break down and reduce waste rather than cover it up.
With world-class research and development, we help industrial and institutional manufacturers and distributors produce effective products with trusted biological concentrates.
Support
Education, tools, and hands-on support to activate
Our collaboration doesn’t end after we ship the product. We’ve seen that our clients succeed when we can provide blending and formulation support as well as training and sales materials, so that the finished product, and its marketing, are effective.
Learn more about our support
Partnerships

Prioritized growth and Long-term Success
We work best with clients who aspire to refine and create products that help them grow. As solution-based partners, we want to see their success by engaging with them to solve unique product challenges and innovating on a continual basis.
Learn more
SporActiv® Technical Support Offerings
News









